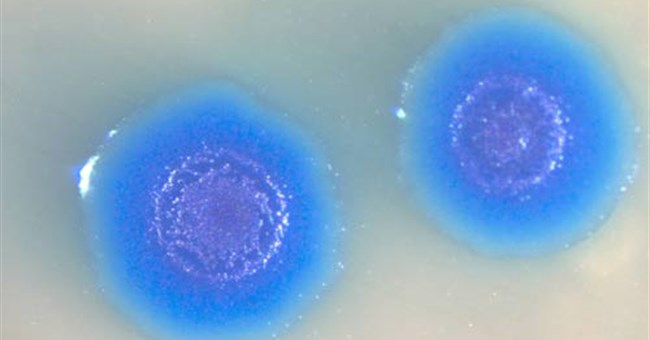
Có thể tạo ra sự sống!

Vì sao Rome được gọi là “Thành phố vĩnh cửu“?

Theo một truyền thuyết cổ xưa, thủ đô Rome của Italy được lập thành vào năm 753 trước Công nguyên bởi Romulus - vị vua đầu tiên của người La Mã.
Dải Ngân hà đang mở rộng nhanh hơn tốc độ âm thanh

Nghiên cứu mới chỉ ra dải Ngân hà đang mở rộng với những ngôi sao mới được sinh ra, Space hôm 4/4 đưa tin.
Những "sự tích" thú vị mà bạn chưa từng nghe về Nhật Bản

Những niềm tin dưới đây gắn bó mật thiết với đời sống của người dân Nhật Bản. Hầu hết chúng bắt nguồn từ sự kiện lịch sử, thần thoại, cách chơi chữ cũng chẳng vì lý do gì cụ thể.
Những công trình nổi tiếng được "hồi sinh" từ tàn tích còn sót lại

Với kỹ thuật 3D, nhóm nghiên cứu đã có thể tái hiện lại 6 công trình kiến trúc lịch sử nổi tiếng mà chúng ta ít có cơ hội được chiêm ngưỡng.
Trung Quốc mở cửa cầu trên biển dài nhất thế giới, nối Hongkong và Macau

Được biết, trong tháng 04 này, Trung Quốc sẽ bắt đầu mở cửa cây cầu bắc ngang biển có độ dài kỉ lục lên tới 55 km của mình, nối liền giữa Hongkong và Macau.
Kế hoạch khám phá sao Hỏa bằng robot ong của NASA

Cơ quan Hàng không Vũ trụ Mỹ (NASA) đang lên kế hoạch sử dụng robot bay cỡ nhỏ mang tên Marsbees để khám phá sao Hỏa trong tương lai.
NASA gửi… tinh trùng lên trạm không gian ISS

Các mẫu tinh trùng người và bò vừa theo tàu vũ trụ SpaceX Dragon của NASA đến trạm không gian ISS trong chuyến hàng tiếp tế mới nhất.
Những lầm tưởng về sữa cha mẹ nên hiểu rõ

Thạc sĩ, Dược sĩ cao cấp Trương Minh Đạt, Chánh văn phòng Hiệp hội Thực phẩm Chức năng Việt Nam, chia sẻ về những hiểu lầm trong cách phân biệt các loại sữa dành cho bé.
Bí mật trò ảo thuật "biến mất bức tượng Nữ Thần Tự Do" của David Copperfield

Năm 1983, cả thế giới đã sửng sốt bởi pha trình diễn “ma quỷ” của ảo thuật gia David Copperfield, trước sự chứng kiến của hàng nghìn khán giả và triệu triệu người xem truyền hình trực tiếp, gã “phù thủy” đã “hô biến” bức tượng khổng lồ mang tên “Nữ thần tự do” mất tích không dấu vết.
Chỉ ngắm mây bay cũng có thể đoán được hiểm họa thời tiết

Qua thời gian, nhưng cải tiến trong việc dự báo đã giúp dự báo thời tiết trước 5 ngày cũng chính xác như tiên đoán về thời tiết trước 3 ngày cách đây 20 năm.
Những điều chắc hẳn bạn chưa biết về Hy Lạp

Hy Lạp nổi tiếng với các câu chuyện thần thoại, tuy nhiên bạn sẽ bất ngờ với những sự thật lạ về Hy Lạp.
Tuyệt chiêu đơn giản để nhận biết rau củ quả Trung Quốc

Cách phân biệt họa quả Trung Quốc - Các loại hoa quả Trung Quốc chứa nhiều hóa chất độc hại ngày càng xâm nhập sâu vào thị trường Việt Nam luôn là nỗi ám ảnh của các bà nội trợ. Để nhận biết các loại hoa quả Trung Quốc không quá khó, chỉ cần một chút tinh ý sẽ giúp chị em đảm bảo an toàn sức khỏe cho gia đình.
7 câu đố test IQ mà người ra đề tin rằng chỉ ai học xong thạc sĩ mới làm đúng hết

Cư dân mạng thực sự rất thích trò chơi giải đố, đơn giản là vì nó giúp chúng ta thư giãn, đồng thời lại giúp não bộ tập luyện tư duy thật hiệu quả.
 Mặc dù các nghiên cứu chỉ ra rằng người La Mã cổ đại đã đào hố làm “tủ lạnh”, tuy nhiên cách làm cụ thể vẫn chưa được làm rõ.
Mặc dù các nghiên cứu chỉ ra rằng người La Mã cổ đại đã đào hố làm “tủ lạnh”, tuy nhiên cách làm cụ thể vẫn chưa được làm rõ. Du khách Josephine Williams chứng kiến tắc kè hoa vật lộn để thoát khỏi rắn boomslang (Dispholidus typus) trong công viên quốc gia Kruger, Nam Phi, Earth Touch News hôm 3/4 đưa tin.
Du khách Josephine Williams chứng kiến tắc kè hoa vật lộn để thoát khỏi rắn boomslang (Dispholidus typus) trong công viên quốc gia Kruger, Nam Phi, Earth Touch News hôm 3/4 đưa tin. Trong suốt 5 kỷ nguyên kéo dài 500 triệu năm qua, các nhà khoa học ước tính rằng đã có khoảng 50 – 90% các loài sinh vật đã phải ngậm ngùi chịu cảnh bị xóa sổ toàn bộ trên mặt đất.
Trong suốt 5 kỷ nguyên kéo dài 500 triệu năm qua, các nhà khoa học ước tính rằng đã có khoảng 50 – 90% các loài sinh vật đã phải ngậm ngùi chịu cảnh bị xóa sổ toàn bộ trên mặt đất. Micro Dragon là vệ tinh quan sát Trái đất, có trọng lượng 50kg, kích thước 50 x 50 x 50cm.
Micro Dragon là vệ tinh quan sát Trái đất, có trọng lượng 50kg, kích thước 50 x 50 x 50cm. Hành tinh bí ẩn được phát hiện bởi một nhóm các nhà thiên văn học toàn cầu bao gồm Đại học Warwick.
Hành tinh bí ẩn được phát hiện bởi một nhóm các nhà thiên văn học toàn cầu bao gồm Đại học Warwick. Vâng, Wifi - mạng không dây, hiện đã và đang chiếm vai trò rất quan trọng trong cuộc sống, công việc cũng như giải trí thường ngày của chúng ta.
Vâng, Wifi - mạng không dây, hiện đã và đang chiếm vai trò rất quan trọng trong cuộc sống, công việc cũng như giải trí thường ngày của chúng ta. Thành tựu này có thể giúp các nhà nghiên cứu phát triển những bộ não người lớn hơn. Trong tương lai, họ hy vọng sử dụng tế bào bộ não này để điều trị cho các bệnh nhân đột quỵ.
Thành tựu này có thể giúp các nhà nghiên cứu phát triển những bộ não người lớn hơn. Trong tương lai, họ hy vọng sử dụng tế bào bộ não này để điều trị cho các bệnh nhân đột quỵ. Theo một truyền thuyết cổ xưa, thủ đô Rome của Italy được lập thành vào năm 753 trước Công nguyên bởi Romulus - vị vua đầu tiên của người La Mã.
Theo một truyền thuyết cổ xưa, thủ đô Rome của Italy được lập thành vào năm 753 trước Công nguyên bởi Romulus - vị vua đầu tiên của người La Mã. Nghiên cứu mới chỉ ra dải Ngân hà đang mở rộng với những ngôi sao mới được sinh ra, Space hôm 4/4 đưa tin.
Nghiên cứu mới chỉ ra dải Ngân hà đang mở rộng với những ngôi sao mới được sinh ra, Space hôm 4/4 đưa tin. Những niềm tin dưới đây gắn bó mật thiết với đời sống của người dân Nhật Bản. Hầu hết chúng bắt nguồn từ sự kiện lịch sử, thần thoại, cách chơi chữ cũng chẳng vì lý do gì cụ thể.
Những niềm tin dưới đây gắn bó mật thiết với đời sống của người dân Nhật Bản. Hầu hết chúng bắt nguồn từ sự kiện lịch sử, thần thoại, cách chơi chữ cũng chẳng vì lý do gì cụ thể. Với kỹ thuật 3D, nhóm nghiên cứu đã có thể tái hiện lại 6 công trình kiến trúc lịch sử nổi tiếng mà chúng ta ít có cơ hội được chiêm ngưỡng.
Với kỹ thuật 3D, nhóm nghiên cứu đã có thể tái hiện lại 6 công trình kiến trúc lịch sử nổi tiếng mà chúng ta ít có cơ hội được chiêm ngưỡng. Được biết, trong tháng 04 này, Trung Quốc sẽ bắt đầu mở cửa cây cầu bắc ngang biển có độ dài kỉ lục lên tới 55 km của mình, nối liền giữa Hongkong và Macau.
Được biết, trong tháng 04 này, Trung Quốc sẽ bắt đầu mở cửa cây cầu bắc ngang biển có độ dài kỉ lục lên tới 55 km của mình, nối liền giữa Hongkong và Macau. Cơ quan Hàng không Vũ trụ Mỹ (NASA) đang lên kế hoạch sử dụng robot bay cỡ nhỏ mang tên Marsbees để khám phá sao Hỏa trong tương lai.
Cơ quan Hàng không Vũ trụ Mỹ (NASA) đang lên kế hoạch sử dụng robot bay cỡ nhỏ mang tên Marsbees để khám phá sao Hỏa trong tương lai. Các mẫu tinh trùng người và bò vừa theo tàu vũ trụ SpaceX Dragon của NASA đến trạm không gian ISS trong chuyến hàng tiếp tế mới nhất.
Các mẫu tinh trùng người và bò vừa theo tàu vũ trụ SpaceX Dragon của NASA đến trạm không gian ISS trong chuyến hàng tiếp tế mới nhất. Thạc sĩ, Dược sĩ cao cấp Trương Minh Đạt, Chánh văn phòng Hiệp hội Thực phẩm Chức năng Việt Nam, chia sẻ về những hiểu lầm trong cách phân biệt các loại sữa dành cho bé.
Thạc sĩ, Dược sĩ cao cấp Trương Minh Đạt, Chánh văn phòng Hiệp hội Thực phẩm Chức năng Việt Nam, chia sẻ về những hiểu lầm trong cách phân biệt các loại sữa dành cho bé. Năm 1983, cả thế giới đã sửng sốt bởi pha trình diễn “ma quỷ” của ảo thuật gia David Copperfield, trước sự chứng kiến của hàng nghìn khán giả và triệu triệu người xem truyền hình trực tiếp, gã “phù thủy” đã “hô biến” bức tượng khổng lồ mang tên “Nữ thần tự do” mất tích không dấu vết.
Năm 1983, cả thế giới đã sửng sốt bởi pha trình diễn “ma quỷ” của ảo thuật gia David Copperfield, trước sự chứng kiến của hàng nghìn khán giả và triệu triệu người xem truyền hình trực tiếp, gã “phù thủy” đã “hô biến” bức tượng khổng lồ mang tên “Nữ thần tự do” mất tích không dấu vết. Qua thời gian, nhưng cải tiến trong việc dự báo đã giúp dự báo thời tiết trước 5 ngày cũng chính xác như tiên đoán về thời tiết trước 3 ngày cách đây 20 năm.
Qua thời gian, nhưng cải tiến trong việc dự báo đã giúp dự báo thời tiết trước 5 ngày cũng chính xác như tiên đoán về thời tiết trước 3 ngày cách đây 20 năm. Hy Lạp nổi tiếng với các câu chuyện thần thoại, tuy nhiên bạn sẽ bất ngờ với những sự thật lạ về Hy Lạp.
Hy Lạp nổi tiếng với các câu chuyện thần thoại, tuy nhiên bạn sẽ bất ngờ với những sự thật lạ về Hy Lạp. Cách phân biệt họa quả Trung Quốc - Các loại hoa quả Trung Quốc chứa nhiều hóa chất độc hại ngày càng xâm nhập sâu vào thị trường Việt Nam luôn là nỗi ám ảnh của các bà nội trợ. Để nhận biết các loại hoa quả Trung Quốc không quá khó, chỉ cần một chút tinh ý sẽ giúp chị em đảm bảo an toàn sức khỏe cho gia đình.
Cách phân biệt họa quả Trung Quốc - Các loại hoa quả Trung Quốc chứa nhiều hóa chất độc hại ngày càng xâm nhập sâu vào thị trường Việt Nam luôn là nỗi ám ảnh của các bà nội trợ. Để nhận biết các loại hoa quả Trung Quốc không quá khó, chỉ cần một chút tinh ý sẽ giúp chị em đảm bảo an toàn sức khỏe cho gia đình. Cư dân mạng thực sự rất thích trò chơi giải đố, đơn giản là vì nó giúp chúng ta thư giãn, đồng thời lại giúp não bộ tập luyện tư duy thật hiệu quả.
Cư dân mạng thực sự rất thích trò chơi giải đố, đơn giản là vì nó giúp chúng ta thư giãn, đồng thời lại giúp não bộ tập luyện tư duy thật hiệu quả.